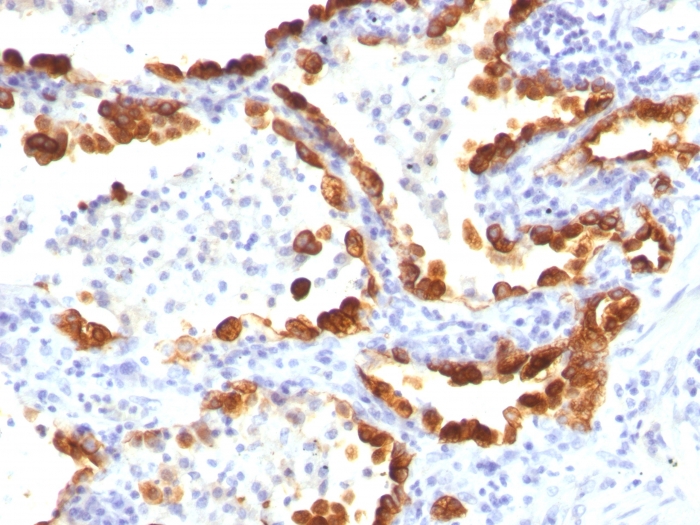

Formalin-fixed, paraffin-embedded human Lung Cancer stained with Cytokeratin 18 Mouse Monoclonal Antibody (KRT18/835).

Formalin-fixed, paraffin-embedded human Thyroid Cancer stained with Cytokeratin 18 Mouse Monoclonal Antibody (KRT18/835).

Formalin-fixed, paraffin-embedded human Colon Carcinoma stained with Cytokeratin 18 Mouse Monoclonal Antibody (KRT18/835).

Formalin-fixed, paraffin-embedded human Bladder Carcinoma stained with Cytokeratin 18 Mouse Monoclonal Antibody (KRT18/835).

Confocal immunofluorescence image of MCF cells using Cytokeratin 18 Mouse Monoclonal Antibody (KRT18/835) Green (CF488) and Reddot is used to label the nuclei.

SDS-PAGE Analysis Purified Cytokeratin 18 Mouse Monoclonal Antibody (KRT18/835). Confirmation of Integrity and Purity of Antibody.
This MAb reacts with a wide variety of simple epithelia. It does not react with stratified squamous epithelia. It reacts with epithelial tumors of the gastrointestinal tract, lung, breast, pancreas, ovary, and thyroid. Cytokeratin 18, which belongs to the type A (acidic) subfamily of low molecular weight keratins, exists in combination with cytokeratin 8. It is reported that tissues from gastrointestinal tract are positive for both cytokeratin 8 and 18 but do not contain cytokeratin 14. Tissues from gastrointestinal tract, respiratory tract and urogenital tract, as well as endocrine and exocrine tissues and mesothelial cells are positive for cytokeratin 18.
There are no reviews yet.